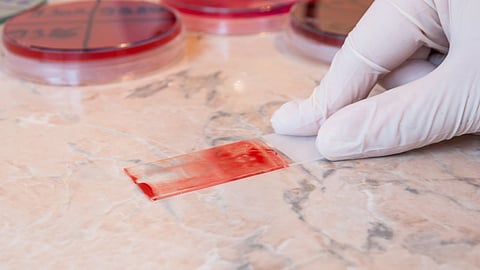
blood smear

- Home
- Health A to Z
- Health A to Z
- Allergies
- Alternative Medicine
- Asthma
- Blood Disorders
- Bone and Joint
- Cancer
- Cardiovascular Diseases
- Caregiving
- Child Health
- Coronavirus
- Cosmetic
- Dental Care
- Diabetes
- Digestive System
- Disabilities
- Drug Center
- Ear, Nose, and Throat
- Environmental Health
- Exercise And Fitness
- Eye Care
- Fertility
- First Aid and Emergencies
- General Health
- Health Technology
- Hearing Loss
- Hypertension
- Infectious Disease
- LGBTQ Health
- Liver Health
- Men's Health
- Mental Health
- Neurology
- Nutrition
- Pain Management
- Pets
- Pregnancy
- Public Health
- Pulmonology
- Senior Health
- Sexual Health
- Skin Health
- Stroke
- Weight Loss
- Women's Health
- News For Medical Professionals
- Video
- Content Licensing
- Custom Content
- About
- Spanish
- Newsletter

